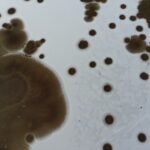

IĞDIR (AA) – Iğdır'da etkili olan soğuk havadan dolayı bazı sulak alanların yüzeyi buz tuttu.
Hava sıcaklığının sıfırın altında 8 dereceye kadar düştüğü ilde dereler dondu.
Türkiye'nin en büyük milli parkı olan Ağrı Dağı Milli Parkı'ndaki sulak alanlar da buzla kaplandı.
Henüz kar yağışının olmadığı, fakat hava sıcaklığının düşmesi nedeniyle donan bölgedeki su kaynakları, drone ile havadan görüntülendi.